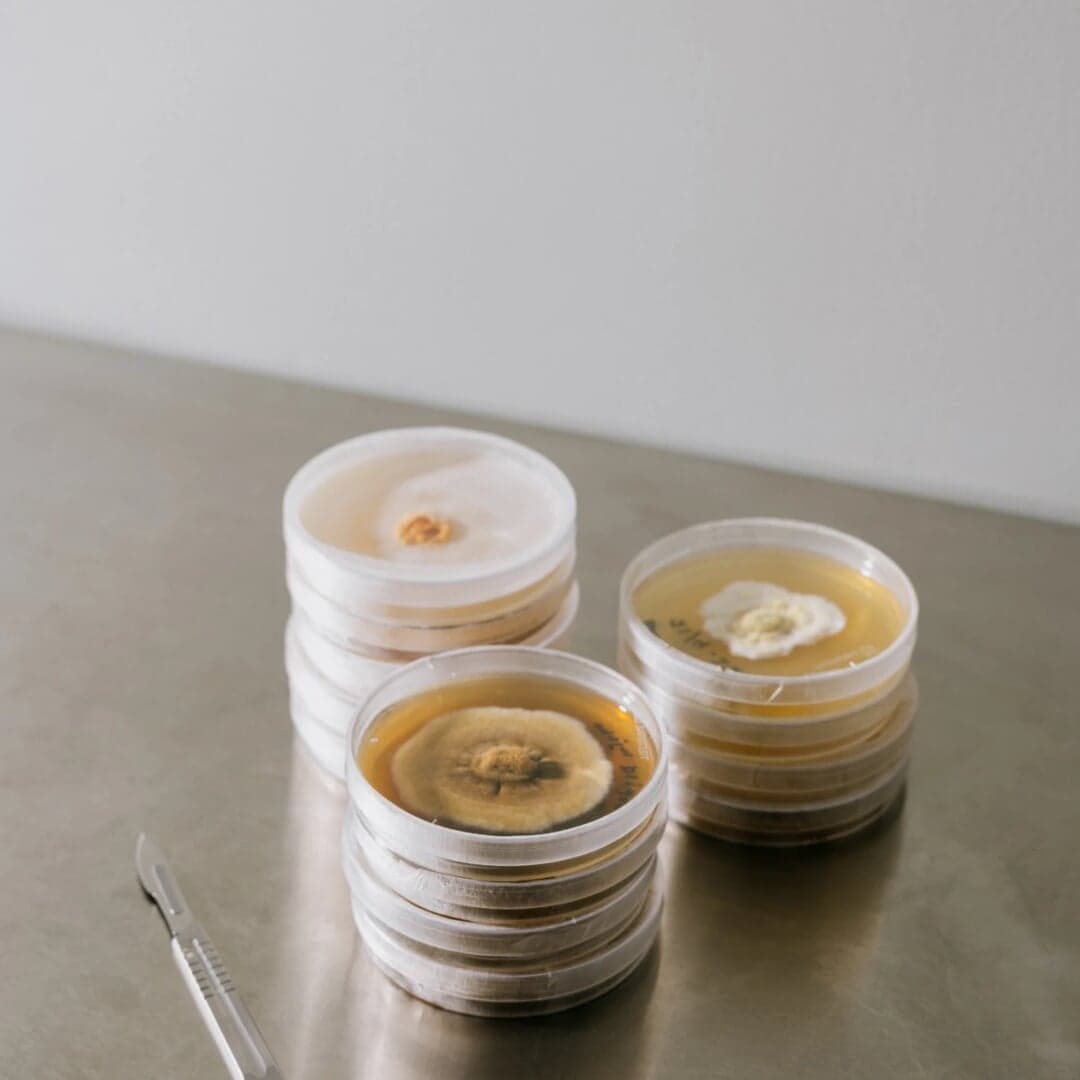
Brand Identity For A Circular Materials Startup

Brand Identity For A Circular Materials Startup
Bleed developed a dynamic and evolving brand identity for Mycela, a cleantech startup creating 100% circular materials from mycelium. The design reflects the natural life cycle of the fungus, blending organic and scientific elements through adaptive color profiles, textured illustrations, and versatile typography.